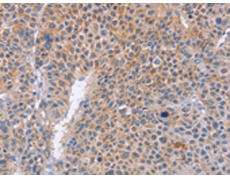
一抗

中文名稱: 兔抗PLK1多克隆抗體
英文名稱: Anti-PLK1 rabbit polyclonal antibody
別 名: PLK; STPK13
相關(guān)類別: 一抗
抗 原: PLK1
儲(chǔ) 存: 冷凍(-20℃)
宿 主: Rabbit
反應(yīng)種屬: Human, Mouse, Rat
標(biāo) 記 物: Unconjugate
克隆類型: rabbit polyclonal
技術(shù)規(guī)格
|
Background: |
Serine/threonine-protein kinase PLK1, also known as polo-like kinase 1 (PLK-1) or serine/threonine-protein kinase 13 (STPK13), is an enzyme that in humans is encoded by the PLK1 (polo-like kinase 1) gene. Plk protein accumulates in the cell during the S and G2 phases of the cell cycle and both protein content and catalytic activity peak at the onset of mitosis, followed by a rapid reduction after mitosis. Plk expression is detectable in mitotically active tissues such as colon and placenta, as well as in tumors of various origins. It has also been suggested that Plk may serve as a marker of cell proliferation. |
|
Applications: |
ELISA, IHC |
|
Name of antibody: |
PLK1 |
|
Immunogen: |
Fusion protein of human PLK1 |
|
Full name: |
polo-like kinase 1 |
|
Synonyms: |
PLK; STPK13 |
|
SwissProt: |
P53350 |
|
ELISA Recommended dilution: |
1000-5000 |
|
IHC positive control: |
Human liver cancer |
|
IHC Recommend dilution: |
25-100 |

 購(gòu)物車
購(gòu)物車 幫助
幫助
 021-54845833/15800441009
021-54845833/15800441009